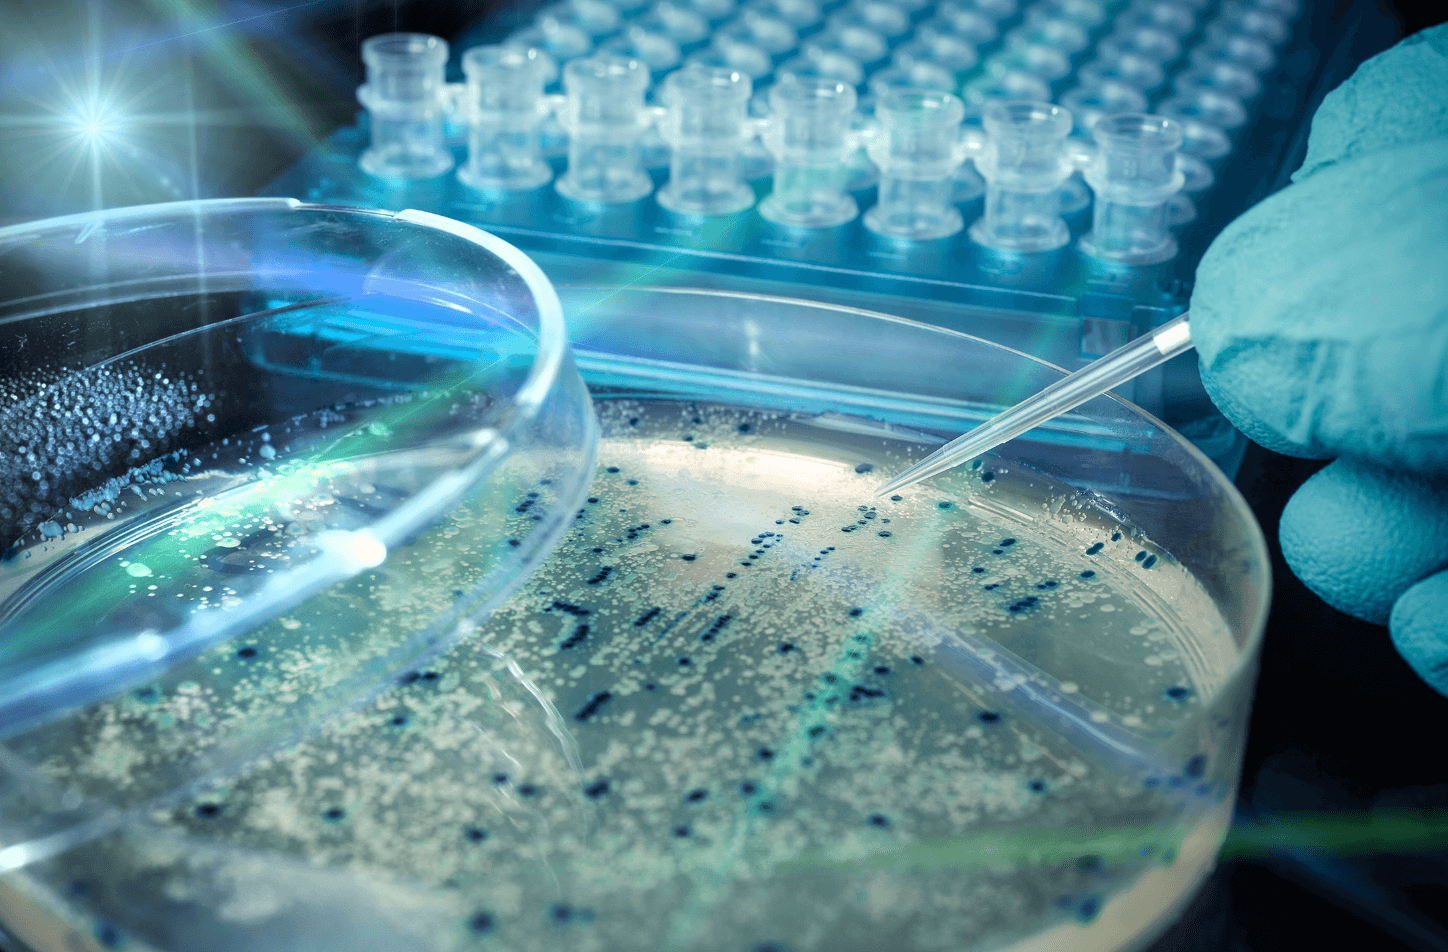

일본 감염병 STSS 증상, 인식 박테리아 예방 치료
- 암 건강
- 2024. 3. 22. 19:25
일본에서 유행 중인 연쇄상 구균 독성 쇼크 증후군(STSS)으로 인하여 전 세계가 시끄러워지고 있습니다. 단순한 감염병인 줄 알았는데 치사율이 30%나 될 만큼 위험하며, 호흡기로 전염될 수 있기 때문에 STSS 증상과 예방에 만전을 기하고 치료 방법에 대한 정보를 미리 알아두는 것이 좋을 거 같아 일본 STSS에 대한 정보를 공유합니다.

일본 STSS
극증형 용혈성 렌사구균 감염이라고 말하는 일본 STSS는 감염에 걸려도 무증상인 경우도 많으며, 대부분 인두염이나 피부의 감염증에서 끝이 나지만, 드물게 혈액, 근육, 폐등에 렌사균이 침입을 합니다.
기본적인 초기증상이 나타나고 얼마 되지 않아 급격하게 병상이 진행되고 아이들이 많이 걸리는 A군 용혈성 렌사구균 인두염과는 구별이 됩니다.
주된 감염 경로는 호흡기인 코와 입으로 감염되거나 접촉 외 상처로부터 감염되는 경우가 있기 때문에 손을 깨끗이 씻고 인파가 많은 곳에 가지 않아야 하며 마스크를 끼고 상처를 청결하게 유지하는 것이 중요합니다.
인식 박테리아라고도 불리며, 현재 감염이 일본에서 기록적인 속도로 확산되어 가고 있으며 30세 이상의 성인에게 심각한 질병, 합병증으로 치사율이 30%나 될 정도로 위험한 감염증입니다.
이질병은 30여 년 전 일본에서 처음 발견되었으며, 살을 파먹는 병으로 알려진 심한 경우 근육조직 괴사로 이어질 수 있으며 일본 보도에 따르면 영향을 받은 사람들의 사망률은 30%입니다.

STSS 증상
STSS 증상은 일반적인 감기 증상과 비슷하지만 초기 증상 발병후 급격하게 근육주변의 괴사를 일으키거나 혈압 저하 다장기 부전으로부터 쇼크 상태에 빠져 발병후 수십 시간에 사망을 할수 있습니다.
▲ STSS 초기 증상
- 사지통증
- 부종
- 발열
- 혈압 저하
사지 통증과 부종 발열등의 징후가 보이는 경우 신속하게 의료기관으로 가는것이 중요하며, 발열은 38도이상 상처와 그주의를 누르면 강력한 통증을 느끼게 됩니다.
이와 더불어 진행이 되면 근육과 근막을 괴사시키고 혈류를 타고 전신으로 돌아, 다기관 부전등을 일으키기도 합니다. 발병후 수십시간내 쇼크 상태에서 사망에 이르기도 하며 치사율은 30% 정도로 알려져 있습니다.
△ STSS 무증상
연쇄상 구균에 걸린 대부분의 사람들은 아무런 증상이 없지만 인후염과 피부에 증상이 나타날수 있습니다. 운이 없는 사람은 박테리아가 혈액, 근육 또는 폐로 퍼지면 증상이 빠르게 악화되어 고혈압, 장기 부전, 극단적인 경우 사망할수 있습니다.
STSS 예방
코로나 19의 재분류가 화농성 연쇄구균 감염 증가의 가장큰 요인이라고 말하는 전문가들이 늘어나고 이으며, STSS는 호흡기로 전염될수 있기 때문에 마스크는 물론 손 소독등 감염 예방을 위한 기본적인 사항을 지켜야 합니다.
STSS 취약한 사람은 박테리아가 피부 병변이나 점막과 같은 손상된 장벽을 통해 신체에 들어갈때 깊은 조직으로 퍼져 혈류로 들어가기 때문에 상처가 나거나 하신 분들은 특히나 상처를 청결하게 관리를 해야 합니다.
"손을 씻고 상처가 있다면 청결하게 관리하는게 중요 합니다."

STSS 치료
STSS 치료방법은 일단 심하지 않은 경우는 항생제를 투여하고, 경과를 지켜본후 나아지지 않으면 다양한 약물 및 필요한 경우 수술을 통해 감염원의 제거가 필요할수 있습니다.
사망율이 30% 인줄 알았는데 CDC(질병통제예방센터)에서는 사망율을 30 ~ 70%로 추정을 하고 있네요. 사망율이 상당히 높기 때문에 STSS에 걸리지 않도록 주의 해야 겠습니다.
최근 우리나라 사람들이 일본엔화 약세로 많이들 일본여행을 가고 있는데, 이러한 기사들이 떠서 여행 가지 말라는 언론의 조작이 아닐까 열심히 찾아보았습니다. 그런데 각국의 나라에서 지금 일본의 STSS 상황을 지켜보고 있고 당분간 주의를 해야 할것 같습니다.
이상으로 일본 감염병 STSS 증상, 인식 박테리아 예방 치료 포스팅을 줄입니다.
엠폭스 바이러스 증상 치사율
원숭이 두창으로 알려진 엠폭스 바이러스는 국내에서 드물지만 잠재적으로 심각한 질병으로 알려져 있습니다. 엠폭스 바이러스는 감염된 사람, 동물 및 바이러스에 오염된 물질로부터 퍼질 수
bluelsm.com
메르스 사스 코로나19 치사율 비교
이번 코로나19만 코로나바이러스가 아닙니다. 메르스(MERS), 사스(SARS) 또한 코로나바이러스의 한종류입니다. 즉 이모든 호흡기 바이러스는 특정 동물에게서 인간으로 전염이되어 발생한 신종바
bluelsm.com
'암 건강' 카테고리의 다른 글
| 대장내시경 용종제거 비용 실비 보험 진단비 (0) | 2024.04.21 |
|---|---|
| 여자 왼쪽 가슴 찌릿 통증 원인 (1) | 2024.04.09 |
| 오라팡 효과 부작용 가격 후기 (3) | 2024.04.06 |
| 사과당근주스 효능 만들기 한달 효과 (0) | 2024.03.28 |
| 입안 점액낭종 원인 증상 치료 (0) | 2024.03.19 |
| 녹용 먹는법 뉴질랜드, 러시아 녹용 가격 추천 (0) | 2024.03.16 |
| 목 여드름 원인, 목드름 없애는법 (0) | 2024.03.13 |
| 이마 지방종 제거 수술 원인 (0) | 2024.03.07 |
이 글을 공유하기






